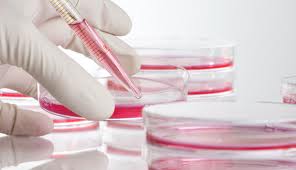

Υγεία
04.02.2014
Πάτρα: Δεύτερος θάνατος από σταφυλόκοκκο σ’ένα μήνα
Σε λιγότερο από ένα μήνα θρήνησε η Πάτρα το δεύτερο θύμα της από σταφυλόκοκκο, γεγονός που έχει προκαλέσει ανησυχία, δεδομένου ότι αμφότεροι οι άνρωποι που χάθηκαν, ήταν υγιείς και νεαροί σε ηλικία. Σύμφωνα με το thebest.gr, ένας 42χρονος, υδραυλικός στο επάγγελμα και πατέρας τριών παιδιών, έχασε τη ζωή του χτυπημένος από σταφυλόκοκκο. Ο άτυχος άνδρας, […]